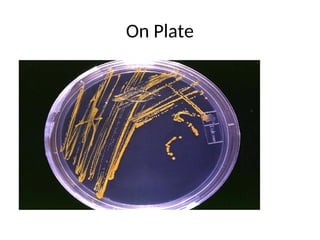
On Plate

The document outlines a comprehensive course on general microbiology, focusing on the structure, classification, and economic importance of microorganisms such as bacteria, fungi, viruses, and protozoa. It includes details on practical laboratory techniques, microbial physiology, public health implications, and the historical development of microbiology as a science. The course aims to provide learners with a foundational understanding of microbiology through lectures, practical exercises, and assessments.